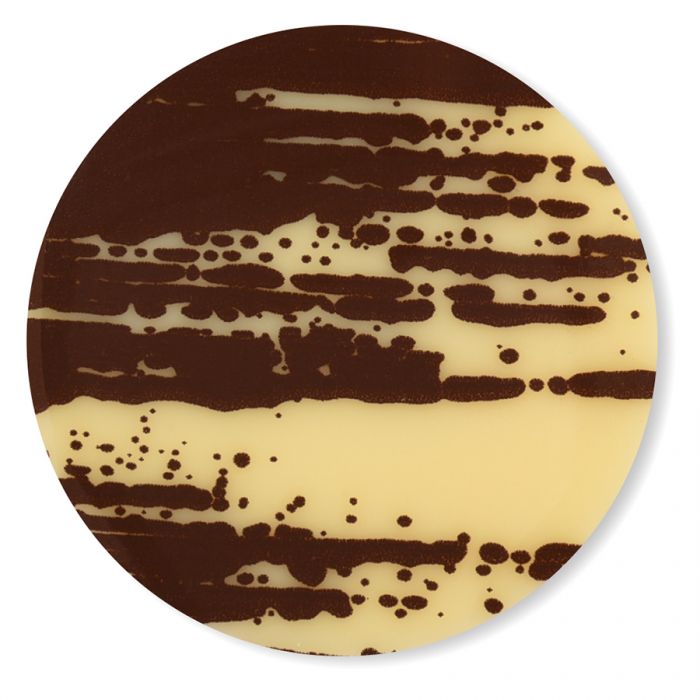
Tondo

Tondo chablon in cioccolato bianco - Marrone
Codice 92154 | Disponibilità - 48
Disponibile
SKU
92154



Dettagli prodotto:
Dimensione D2,8
240 pezzi per confezione
Materiale Cioccolato Bianco
Tondo chablon in cioccolato bianco - Marrone



Dettagli prodotto:
Dimensione D2,8
240 pezzi per confezione
Materiale Cioccolato Bianco
Tondo chablon in cioccolato bianco - Marrone
Solo gli utenti registrati possono scaricare la scheda tecnica. Login/Registrazione o crea un account
Scrivi la tua recensione